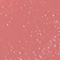

Fast Base Blush Stick
الوصف
عصا أحمر خدود كريمي.
أضيفي لونًا متوهجًا إلى بشرتك مع Makeup Revolution’s Fast Base Blush. متوفر في مجموعة من الظلال الندية الرائعة ، يندمج بسهولة على البشرة للحصول على توهج بسهولة تامّة ، مما سيعمل على ابراز إطلالة مكياجك . للحصول على تدفق صحي للون ، احصلي عليه في مجموعتك.
- لم يتم تجربة المُنتج على الحيوانات
اقرأ المزيد
المكوّنات
Ethylhexyl Palmitate, Tridecyl Trimellitate, Polyethylene, Polybutene, Ceresin, Di-C20-40 Alkyl Dimer Dilinoleate, Tocopheryl Acetate, Phenoxyethanol, Parfum (Fragrance), Benzyl Benzoate. [+/- May Contain (Peut Contenir): Ci 77491 Iron Oxides), Ci 15850 (Red 7), Ci 77499 (Iron Oxides), Ci 77492 (Iron Oxides), Ci 77891 (Titanium Dioxide), Ci 19140 (Yellow 5), Ci 15985 (Yellow 6), Ci 15850 (Red 6)].
طُرق
استخدمي إصبعك لتطبيق المنتج على خديك.
- استخدمي قميّة أقل من المنتج للحصول على نتيجة خفيفة أو قومي بوضع الطبقات للحصول على مظهر أكثر دراميّة.
التوصيل والإرجاع
مع خاصية التتبع
٥٠٫٠٠ ر.س.
٤٩٩٫٠٠ ر.س. مجانًا للطلبات التي تزيد عن
Express
١٢٥٫٠٠ ر.س.
دولي
ااختاري وجهة أخرى .